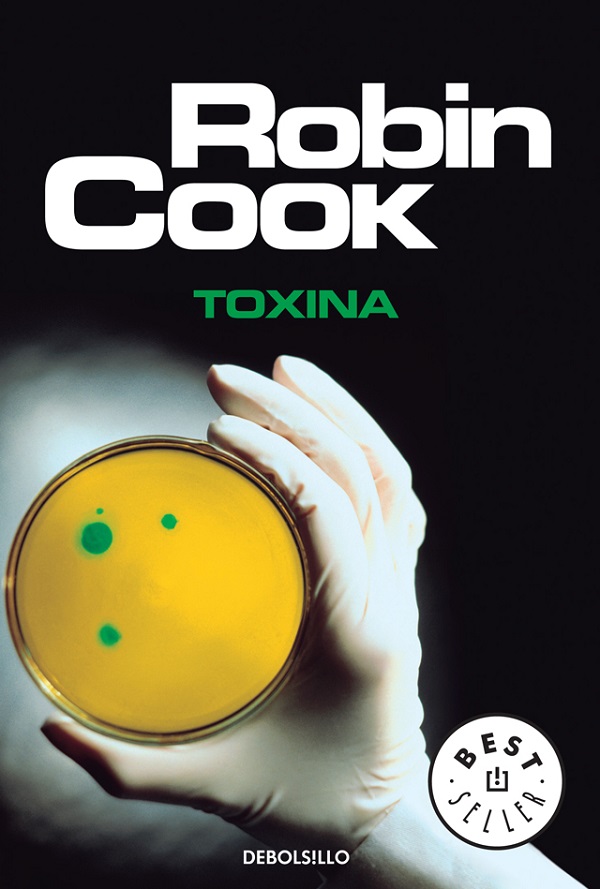

$31.499
Sin existencias
Kim Reggis, un famoso cirujano cardiovascular, lleva a su hija Becky a cenar la típica hamburguesa con patatas fritas, sin imaginar que este acto cotidiano cambiará su vida para siempre. En los días siguientes. Becky caerá gravemente enferma a causa de una intoxicación producida por una bacteria letal. Desesperado ante el inexorable destino de su hija y arriesgándolo todo. Kim decide investigar las causas de la extrana enfermedad, lo que lo conducirá por un laberinto de intereses que anteponen los beneficios económicos al juramento hipocrático, y que salpican hasta las más altas instancias gubernamentales.
Tanto las imágenes o el precio de esta publicación, como cualquier otra información y/o material publicado en este sitio, son a modo ilustrativo y orientativo. Puede ocurrir que no coincida con el producto real. De momento, manejamos más de 21000 productos y pueden surgir errores involuntarios. Sepa comprender. Muchas Gracias!
Administrador web